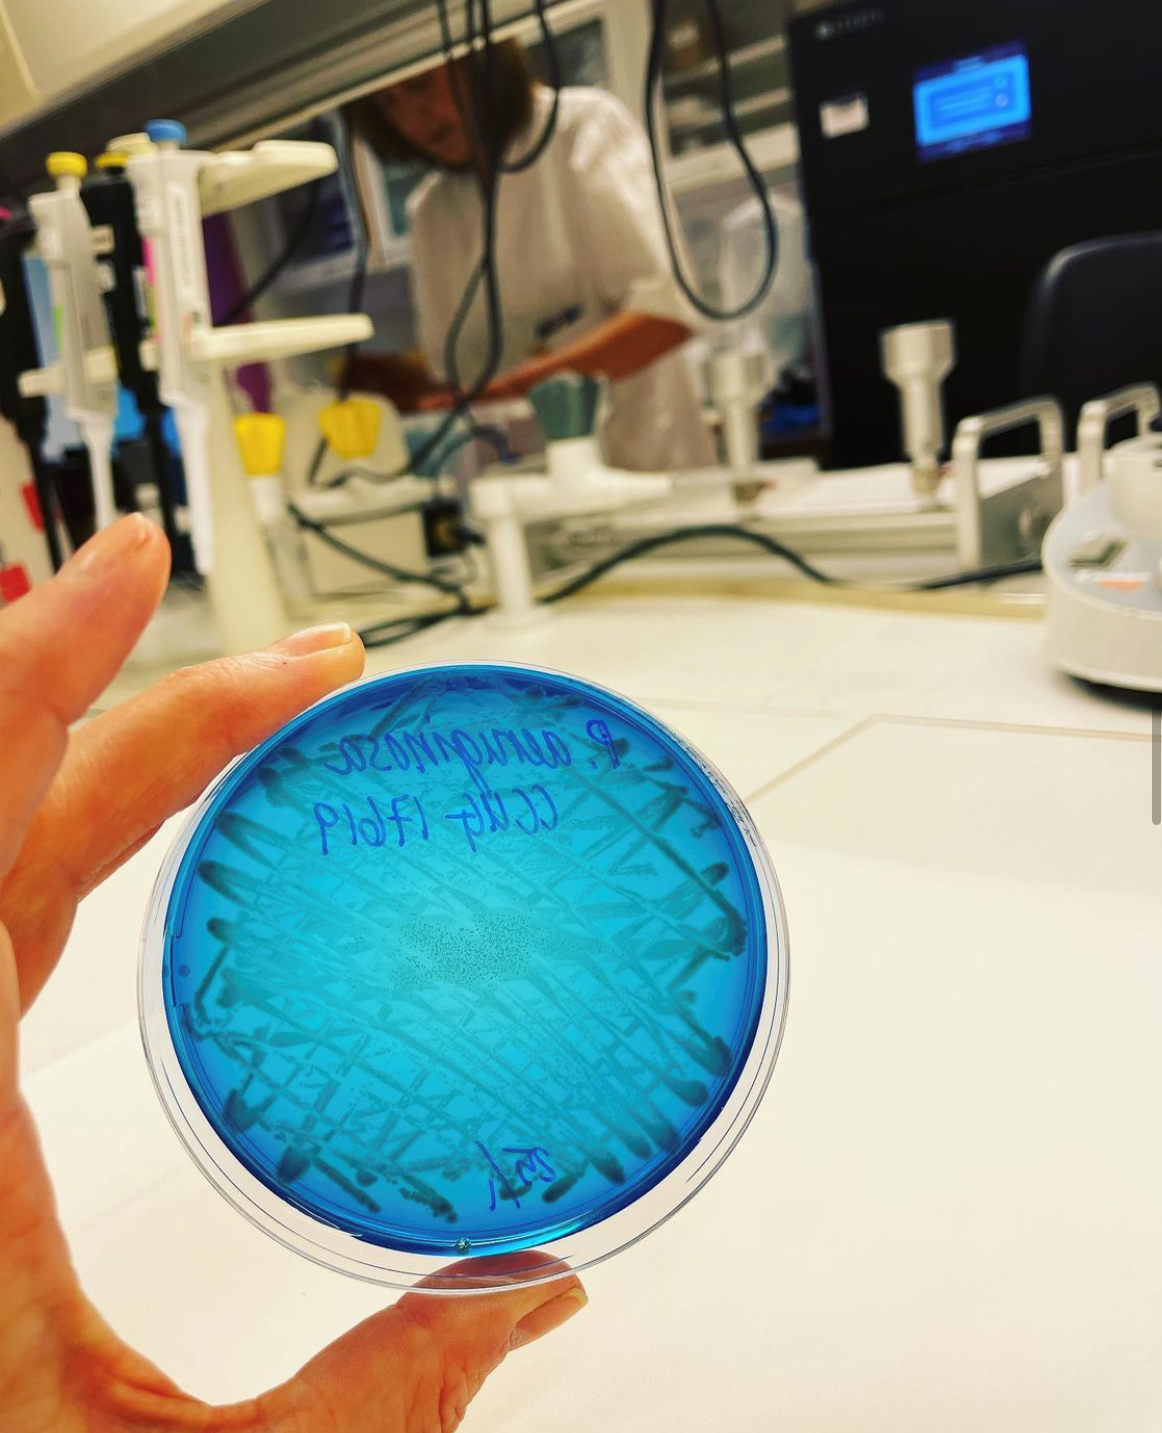
Bildet viser en petriskål med Pseudomonas aeruginosa.

Jakter på håndsydde virus

Smittevern på Oslo universitetssykehus trengte en mer lettbent måte å nå ut på.
Monica Holm er én av dem som jobber i Avdeling for smittevern på Oslo universitetssykehus (OUS). Der er hun labingeniør, med særlig ansvar for dekontaminering.
På Instagram kan hun ikle seg viruskostyme og bli jaget av smittevernoverlegen nedover korridoren. I hygienens tjeneste.
Denne uken tar hun og kollegene over Sykepleiens konto på Instagram. Følg dem her: @Sykepleien
Avdelingen har sin egen Instagram-konto her: @smittevern_ous

Om utstyr og utgang
Leger, hygienesykepleiere, rådgivere, laboranter, labingeniører og valideringsingeniører jobber alle i avdelingen, med samme mål for øye: Å holde alle sykehusets avdelinger mest mulig fritt for sykdomsfremkallende bakterier.
– Vi svarer på veldig mange forskjellige spørsmål, sier Kjersti Hochlin.
Hun har lang erfaring som hygienesykepleier på Ullevål, ett av de fire sykehusene som ligger under OUS.
Mange spørsmål handler om rengjøring av instrumenter og utstyr, om pasienter kan ligge på rom med andre, eller om de kan få gå ut, eller hva med trappetrening.
– Ofte må vi hjelpe til med å treffe tiltak der og da, forteller hun.
– Også til hjelp
Hygienesykepleier Hege Helset, som jobber på Rikshospitalet, sier de ofte iverksetter tiltak som gir merarbeid for klinikerne ute i sykehuset.
Men hun peker på at de også gir råd som er til avlastning og hjelp.
– For eksempel at en pasient kan avisoleres, eller at det ikke er nødvendig å teste for MRSA i dette tilfellet.
– Men vi trengte en mer lettbent måte å kommunisere på, sier Monica Holm.
Sammen byr de derfor på hygienekunnskap i en ny innpakning.

Oppdager stadig nye talenter
Hensikten med kontoen er å formidle kunnskap. Og å bli litt mer synlige i sykehuset.
– Mye av jobben vår er å lage prosedyrer, og tenke smittevern på systemnivå, sier Hege Helset.
De er også rundt i sykehuset og underviser.
– Men da treffer vi åtte, ti, femten stykker om gangen, påpeker hun.
– På Instagram kan vi plutselig nå ut til 800.
Plattformen gir dem mulighet til å påvirke, men de må gjøre det på en annen måte enn ved å holde foredrag.
I stedet lager de blant annet filmsnutter.
– Det virker også samlende i avdelingen, sier Hege Helset.
De stiller opp selv, men spør også kolleger.
– Og vi oppdager stadig nye, komiske talenter, sier hun.

Galskap og fakta
– Det er en fin plattform for å få ut litt galskap, kommenterer Monica Holm.
Men galskapen står aldri alene.
– Vi formidler alltid fakta, understreker Helset.
Temaene er det evige, men akk så kompliserte: Grunnleggende smittevern.
For de har en misjon med kontoen: Og det er å påvirke følgerne i en mer hygienisk retning.

0 Kommentarer